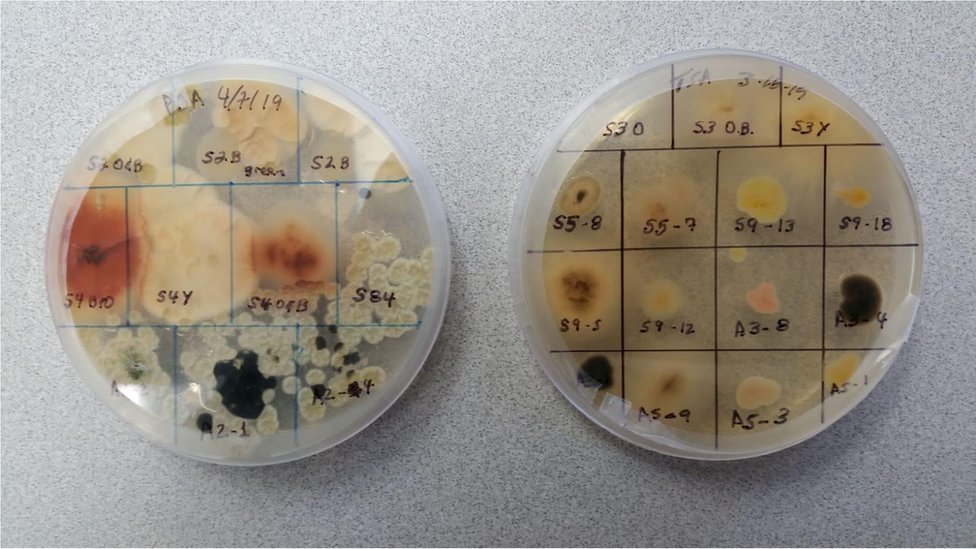
Fungos e bactérias pegam carona nas partículas presentes na fumaça

2020 foi o ano em que imagens de incêndios monstruosos destruindo diversas regiões do mundo foram especialmente marcantes — da Austrália à Califórnia, nos EUA, passando pelo Pantanal e pela Amazônia, no Brasil. Além dos inúmeros estragos e consequências já conhecidos, mais uma ameaça paira no ar: a fumaça dos incêndios florestais pode ser uma nova rota de disseminação de doenças infecciosas, diz um novo estudo científico.
Publicado na revista científica Science, o estudo diz que micróbios e fungos nocivos podem sobreviver em grande número em nuvens de fumaça. Os autores da pesquisa afirmam que é provável que organismos do solo, conhecidos por causar infecções, possam ser espalhados dessa forma.
Eles argumentam que é urgentemente necessário um monitoramento maior da fumaça de incêndios florestais pelas autoridades de saúde. Durante décadas, era amplamente assumido que microorganismos não conseguiram sobreviver na nuvem de fumaça de um incêndio florestal.
Era assumido que a principal ameaça à saúde nas nuvens de fumaça seriam os gases e as cinzas. Partículas microscópicas de fuligem são conhecidas por causarem problemas respiratórios e cardiovasculares..
No entanto, tem havido uma preocupação crescente de que a fumaça do incêndio também possa transportar micróbios ou fungos infecciosos.
O Centro de Controle de Doenças dos Estados Unidos (CDC) afirma que os bombeiros que combatem esses incêndios florestais correm o risco de contrair uma doença pulmonar chamada coccidioidomicose. Essa infecção é causada por um fungo que se espalha no ar quando o solo é remexido.

Os cientistas agora estão começando a descobrir a escala da potencial ameaça infecciosa representada pela fumaça de incêndios florestais.
Usando novas técnicas para capturar microorganismos na fumaça, os pesquisadores dizem que encontraram mais de 900 tipos diferentes de bactérias e cerca de 100 fungos únicos.
"A diversidade de microorganismos que encontramos até agora nos poucos estudos que foram feitos é impressionante", diz Leda Kobziar, da Universidade de Idaho, nos Estados Unidos, que liderou a revisão do estudo.
Os pesquisadores acreditam que os fungos e bactérias pegam carona nas partículas presentes na fumaça.
"Esses grupos de organismos vivos não foram encontrados no ar sem fumaça nos mesmos locais antes do incêndio, provando que a combustão e os ventos associados a ela espalham os micróbios em colunas de fumaça."
Os cientistas encontraram bactérias em abundância 300 metros acima do fogo mesmo em incêndios muito intensos e quentes. Mais de 60% delas eram viáveis, ou seja, poderiam se reproduzir.
Eles suspeitam que as partículas presentes na fumaça nas quais os microorganismos viajam os protegem da radiação ultravioleta, que pode matá-los.
A dúvida principal é o quanto essas bactérias e fungos são de fato uma ameaça à saúde. "Encontramos vários microorganismos que são conhecidos por causar doenças respiratórias comuns — que podem desencadear asma, por exemplo", diz Kobziar, em entrevista por e-mail.
"A probabilidade desses organismos causarem infecção é alta, mas ainda não foi testada experimentalmente."
Estudos anteriores com furacões e tempestades mostraram que esses agentes infecciosos podem viajar distâncias extremamente longas. Mas ninguém ainda sabe qual distância esses causadores de doenças podem viajar em uma nuvem de fumaça.
Mas a capacidade da fumaça de espalhar micróbios pelo mundo sugere que ela pode ser um "elo perdido" para explicar alguns padrões de infecção.

"Quando as infecções são detectadas nos pacientes, os potenciais agentes causais que são examinados são baseados no que é conhecido como endêmico em uma determinada região", diz Kobziar.
"No entanto, a fumaça confunde as linhas entre as regiões. Pode ser que muitos casos de infecção com agentes indeterminados tenham ocorrido devido ao transporte de micróbios pela fumaça para fora de das áreas onde eles são endêmicos. Pode ser que a fumaça seja o elo que faltava para explicar alguns desses padrões de infecção no espaço e no tempo."






0 comentários:
Enviar um comentário